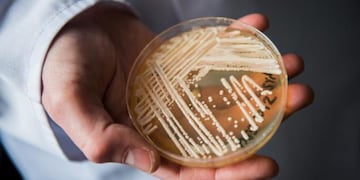
Ya es el tercer caso que se registra del "Súper Hongo" en Brasil.

Vía Eldorado
Robo en una estación de servicio en Bernardo de Irigoyen
El violento episodio se produjo en horas de la madrugada de la jornada de ayer, donde a punta de pistola, asaltaron y redujeron a los empleados. Los delincuentes arribaron al lugar en un vehículo con patente brasileña.